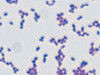

▲Arp 147周遭發現人類史上最大黑洞。(圖/取自NASA官網)
國際中心/綜合報導
據外媒報導,NASA在距地球13億光年外的Arp 147星系中,拍到了一幅環狀圖,經證明這可能是人類史上發現到的最大黑洞;而經過進一步研究,在Arp 147的周圍可能還存在更多巨型黑洞,它們的質量至少是太陽的100億到400億倍。
科學家們發現的巨大黑洞,遠遠超過了他們最初預期的數量;史丹佛大學(Leland Stanford Junior University)的天文學家朱莉(Julie Hlavacek-Larrondo)針對18個星系進行調查,發現其中至少有10個星系擁有質量超過太陽400億倍以上的黑洞。
之前在銀河系中心發現的最大黑洞,質量約為太陽64億倍,但現在發現的這些黑洞,巨大的程度甚至用「超」來形容也不夠貼切,幾乎每個的質量都超過太陽的100億倍以上。
為了估計尺寸,朱莉和她的同事試圖透過黑洞放出的X射線及無線電波來分析,他們認為,這些黑洞所藏有的質量應該會更高。

讀者迴響